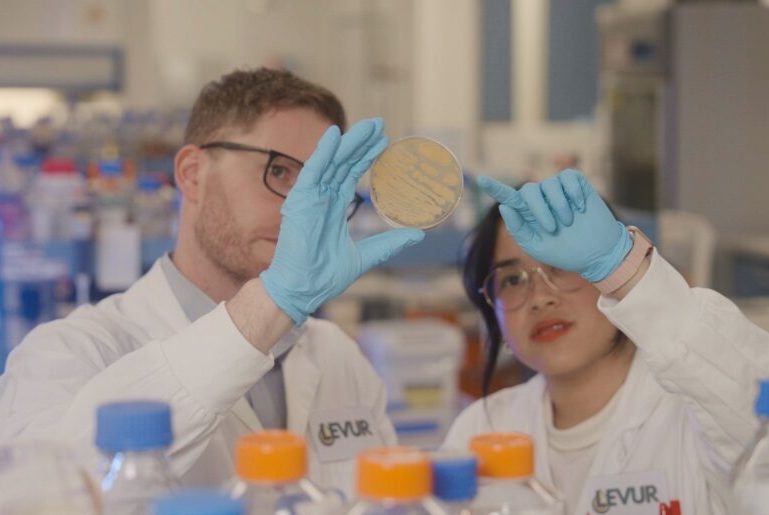

Palm oil is both important to everything from food to cosmetics and detergents, and an environmental disaster, with rainforests being felled for the cash crop.
It’s estimated to be in 50% of all Western household and food products, with 75 million tonnes produced annually. It’s also the leading cause of orangutan extinction, with between 1,000 and 5,000 of the primates killed every year.
So finding an alternative is a win for nature and a Sydney startup that’s just raised $1.2 million in pre-Seed funding is hoping its lab-grown version can do just that.
The round for Levur, based at Macquarie University, was led by CSIRO-backed deep tech fund Main Sequence and GrainCorp Ventures with support from SparkLabs Cultiv8 and the UNSW Founders program.
The startup has designed a system that guides yeast to produce oils through a process similar to brewing beer.
Earlier this year, Levur won the annual $100,000 KPMG Nature Positive Challenge, and last year was part of the 2024 SparkLabs Cultiv8 cleantech agri-tech accelerator, where they initially invested.
Founder and Tom Collier said their research promises a new era of sustainable ingredient production.
“Ingredient production has remained largely unchanged for decades, but we now have the tools to harness biology with precision,” he said.
“At Levur, we’re using advanced strain engineering to create high-performance ingredients that fit seamlessly into existing supply chains, without the environmental trade-offs of traditional industries like palm oil.”
GrainCorp Head of Investments Jordan Jeffery says the technology is an exciting step forward.
“Our teams are committed to reducing environmental impacts across the supply chain, as well as using sustainable and fully traceable ingredients – Levur’s technology ticks all of these boxes,” he said.
“Levur’s solution has the potential to meet these needs at scale, so we’re excited to support them in bringing their innovation to market.”
The Levur investment is the third by GrainCorp Ventures this financial year, alongside Calice and BioScout – startups set to benefit growers through the use of AI and data modelling.

Daily startup news and insights, delivered to your inbox.